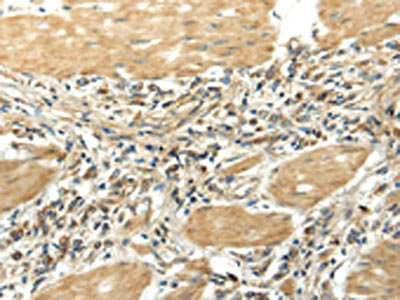

EFNA3 Antibody
-
中文名稱:EFNA3兔多克隆抗體
-
貨號(hào):CSB-PA561188
-
規(guī)格:¥1100
-
圖片:
-
The image on the left is immunohistochemistry of paraffin-embedded Human liver cancer tissue using CSB-PA561188(EFNA3 Antibody) at dilution 1/25, on the right is treated with fusion protein. (Original magnification: ×200)
-
The image on the left is immunohistochemistry of paraffin-embedded Human gastric cancer tissue using CSB-PA561188(EFNA3 Antibody) at dilution 1/25, on the right is treated with fusion protein. (Original magnification: ×200)
-
-
其他:
產(chǎn)品詳情
-
Uniprot No.:
-
基因名:
-
別名:EFL 2 antibody; EFL-2 antibody; EFL2 antibody; EFN A3 antibody; EFNA 3 antibody; Efna3 antibody; EFNA3_HUMAN antibody; EHK1 L antibody; EHK1 ligand antibody; EHK1-L antibody; EHK1L antibody; EPH related receptor tyrosine kinase ligand 3 antibody; EPH-related receptor tyrosine kinase ligand 3 antibody; Ephrin-A3 antibody; EphrinA3 antibody; EPLG 3 antibody; EPLG3 antibody; LERK 3 antibody; LERK-3 antibody; LERK3 antibody; Ligand of eph related kinase 3 antibody
-
宿主:Rabbit
-
反應(yīng)種屬:Human,Mouse
-
免疫原:Fusion protein of Human EFNA3
-
免疫原種屬:Homo sapiens (Human)
-
標(biāo)記方式:Non-conjugated
-
抗體亞型:IgG
-
純化方式:Antigen affinity purification
-
濃度:It differs from different batches. Please contact us to confirm it.
-
保存緩沖液:-20°C, pH7.4 PBS, 0.05% NaN3, 40% Glycerol
-
產(chǎn)品提供形式:Liquid
-
應(yīng)用范圍:ELISA,IHC
-
推薦稀釋比:
Application Recommended Dilution ELISA 1:2000-1:5000 IHC 1:25-1:100 -
Protocols:
-
儲(chǔ)存條件:Upon receipt, store at -20°C or -80°C. Avoid repeated freeze.
-
貨期:Basically, we can dispatch the products out in 1-3 working days after receiving your orders. Delivery time maybe differs from different purchasing way or location, please kindly consult your local distributors for specific delivery time.
-
用途:For Research Use Only. Not for use in diagnostic or therapeutic procedures.
相關(guān)產(chǎn)品
靶點(diǎn)詳情
-
功能:Cell surface GPI-bound ligand for Eph receptors, a family of receptor tyrosine kinases which are crucial for migration, repulsion and adhesion during neuronal, vascular and epithelial development. Binds promiscuously Eph receptors residing on adjacent cells, leading to contact-dependent bidirectional signaling into neighboring cells. The signaling pathway downstream of the receptor is referred to as forward signaling while the signaling pathway downstream of the ephrin ligand is referred to as reverse signaling.
-
基因功能參考文獻(xiàn):
- E2F3 and ephrin A3 are putative targets of miR-210, and their protein expression was up-regulated in the angiosarcoma cells PMID: 28739548
- Results show that EFNA3 serves as a tumor suppressor in malignant peripheral nerve sheath tumor cells and it may play a critical role in the FAK signaling and VEGF-associated tumor angiogenesis pathway. PMID: 25955218
- The present study provides evidence that microglia upregulates endothelial ephrin-A3 and ephrin-A4 to facilitate in vitro angiogenesis of brain endothelial cells, which is mediated by microglia-released TNF-alpha. PMID: 25070915
- EphA2/ephrin-A3 interactions may play a role in the localization and network of Langerhans cells in the epithelium and in the regulation of their trafficking. PMID: 12907451
- analysis of molecular surfaces in ephrin-A5 essential for a functional interaction with EphA3 PMID: 15901737
- MicroRNA-210 modulates endothelial cell response to hypoxia and inhibits the receptor tyrosine kinase ligand Ephrin-A3. PMID: 18417479
- EphA3 mutants with constitutively-released kinase domains efficiently support shedding, even when their kinase is disabled. Our data suggest that this phosphorylation-activated conformational switch of EphA3 directly controls ADAM-mediated shedding. PMID: 19823572
顯示更多
收起更多
-
亞細(xì)胞定位:Cell membrane; Lipid-anchor, GPI-anchor.
-
蛋白家族:Ephrin family
-
組織特異性:Expressed in brain, skeletal muscle, spleen, thymus, prostate, testis, ovary, small intestine, and peripheral blood leukocytes.
-
數(shù)據(jù)庫鏈接:
Most popular with customers
-
-
YWHAB Recombinant Monoclonal Antibody
Applications: ELISA, WB, IHC, IF, FC
Species Reactivity: Human, Mouse, Rat
-
Phospho-YAP1 (S127) Recombinant Monoclonal Antibody
Applications: ELISA, WB, IHC
Species Reactivity: Human
-
-
-
-
-